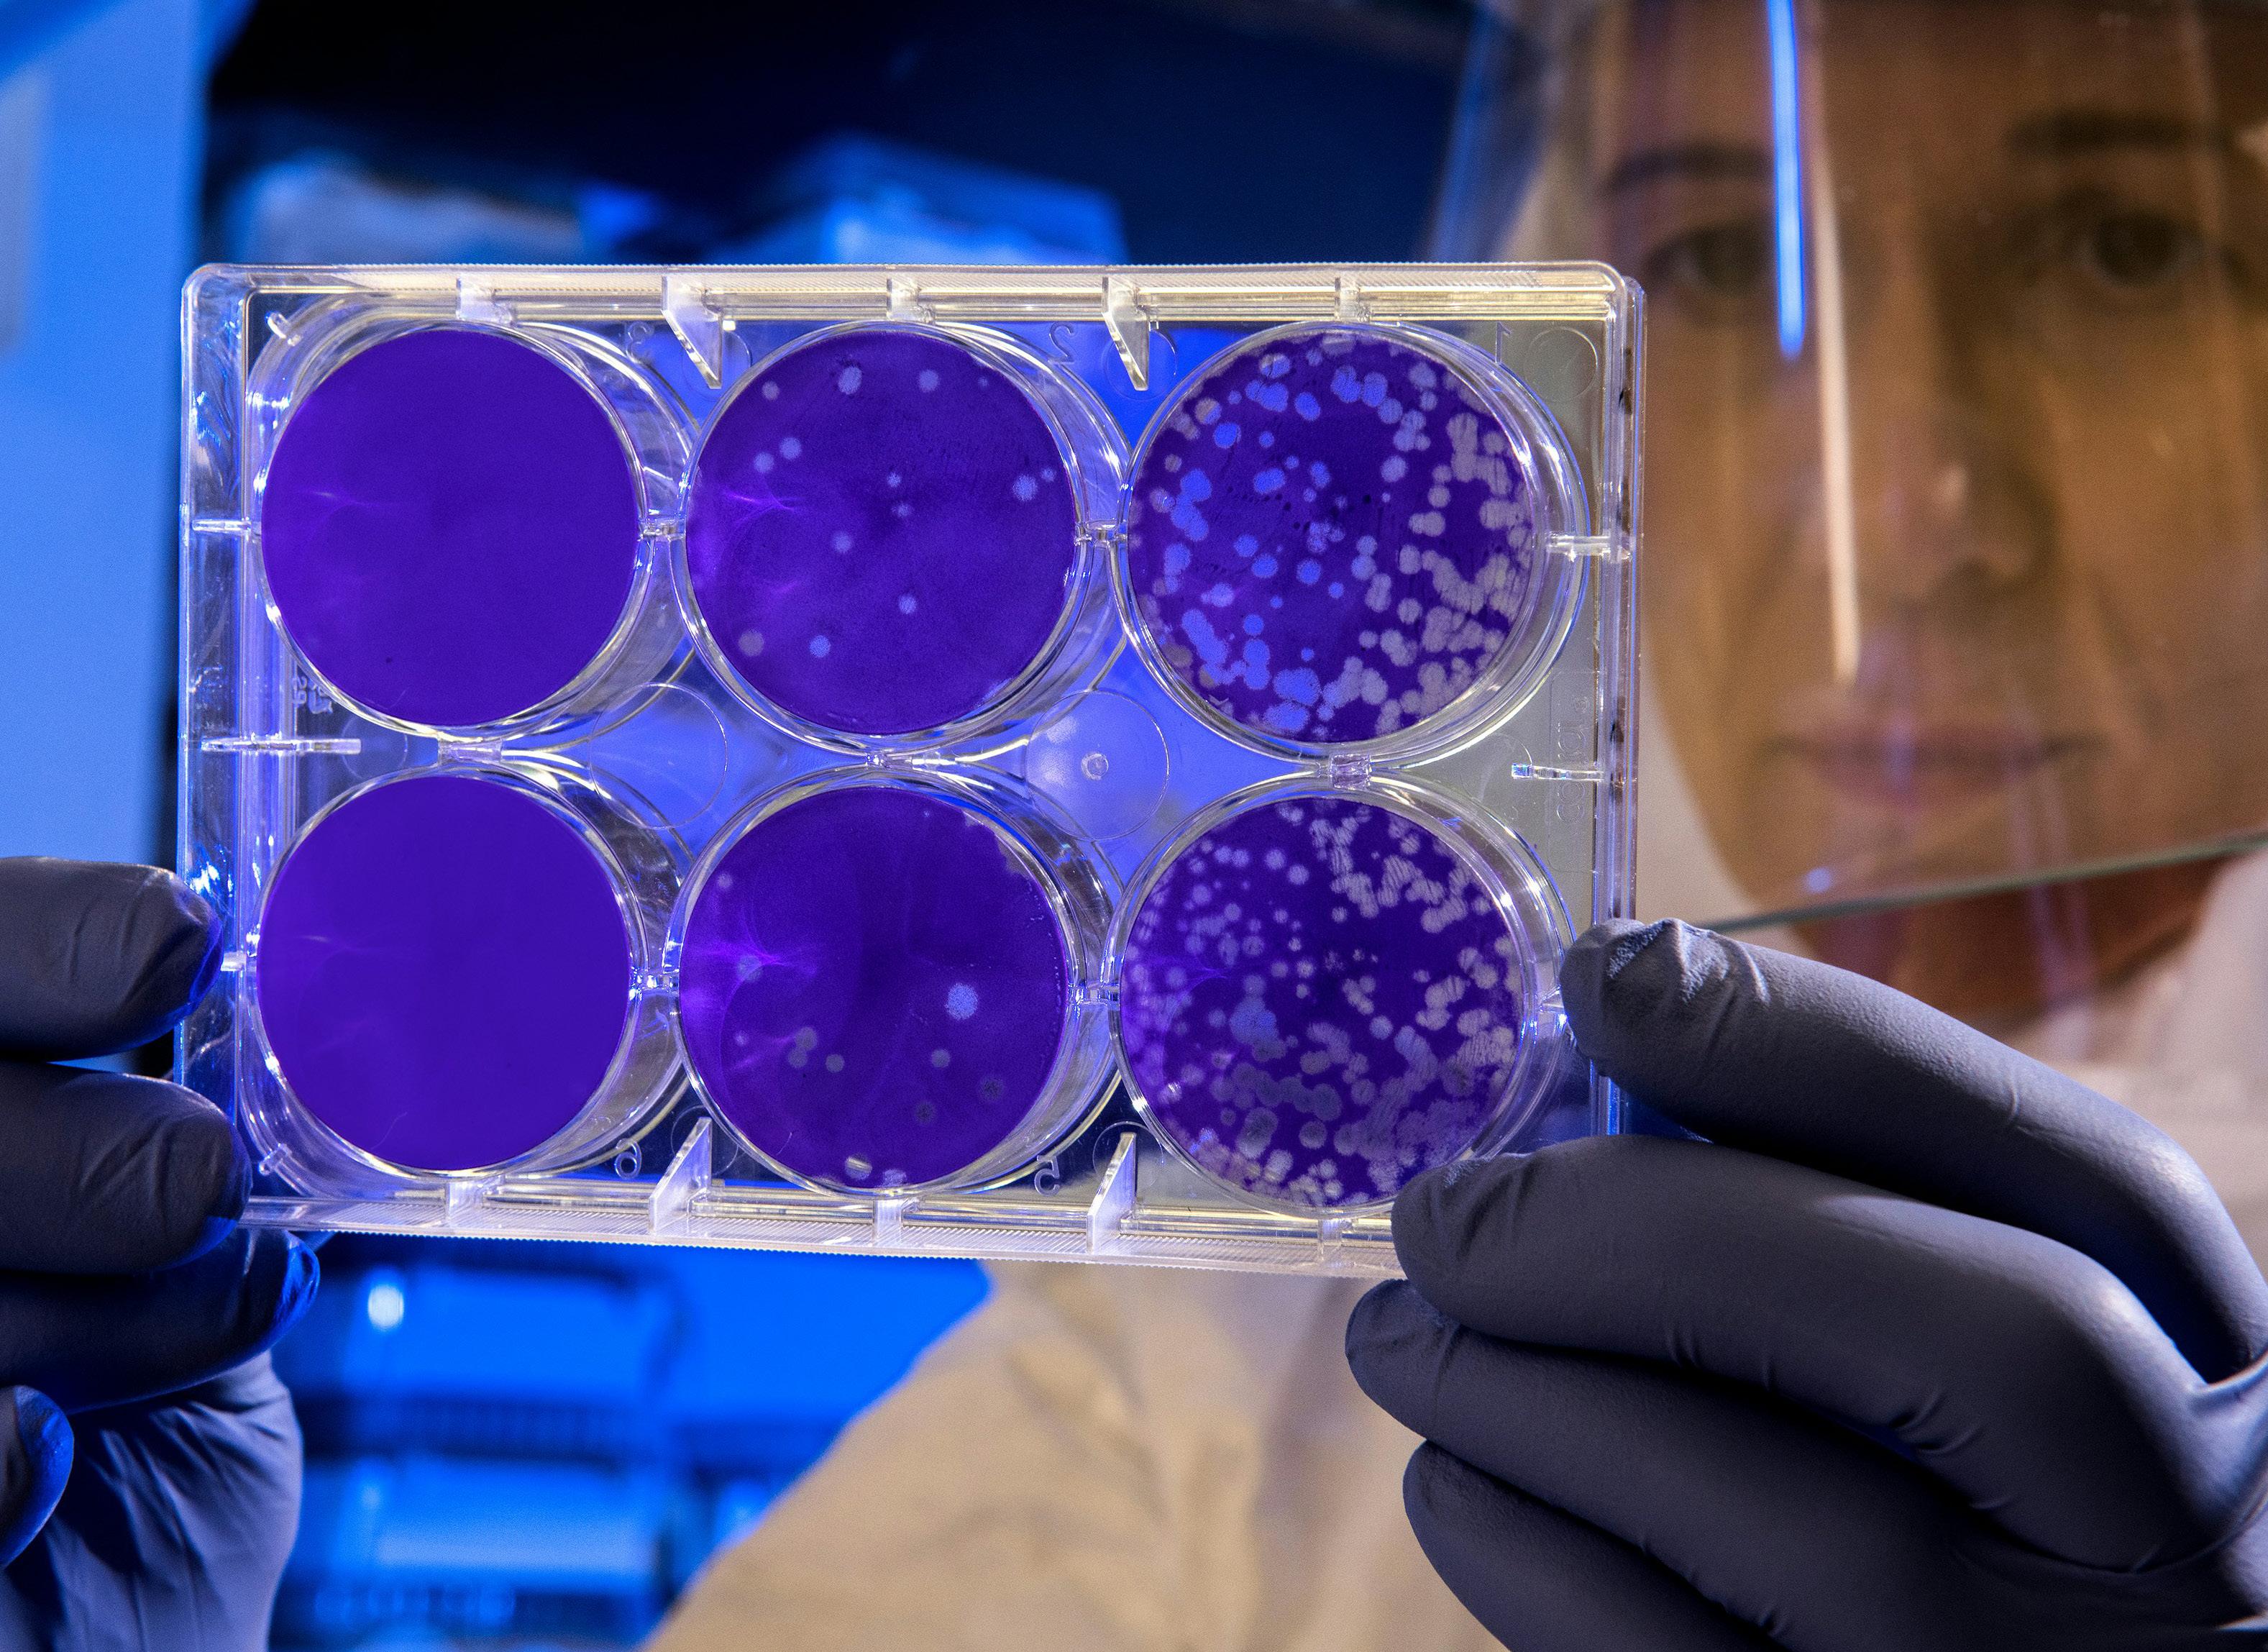

LIVING WITH LUPUS
When should you apply for social security disability when you have lupus?
Emily E. Warren, Esq., pg. 20

What can be done to help prepare you for life with lupus?


When should you apply for social security disability when you have lupus?
Emily E. Warren, Esq., pg. 20

What can be done to help prepare you for life with lupus?

During a brainstorming session, the team talked about the concept of “being covered”, and knowing how to be prepared to deal with your lupus and be comfortable when symptoms strike. It brought to mind how soothing blankets can be and that they cover us and provide comfort when we use them, especially when our lupus is acting up!
Thanks to my extended lupus family, I have an abundance of blankets at home. Some have my face on them (kind of scary). Four others have angels gracefully adorning them. Another has piano keys, my name, butterflies, and more. These blankets have all been gifts of love to me, and I am grateful. They comfort me when I need them, and I smile while my heart tingles as I recall who gifted them to me.
Like many of you, I have good days and challenging days. My body is very sensitive to the changes in weather. When it’s raining or snowing, my pain often increases. This is when I reach for a blanket. What to do but cozy up with something warm and inviting.
Recently, a volunteer whose hobby is quilting walked in here with a giant lavender hand-quilted, queen-size quilt. She apologized for not being able to volunteer at one of our events. Thus, she donated this beautiful quilt to the foundation to be used as a future prize. I am anxious to share it with you soon. I was overwhelmed by her gift of her time and passion to create this beautiful piece. Can you imagine? Thank you, Diane, for your wonderful gift. This is a blanket of love. I know that it will offer great comfort to someone soon.
I do not doubt that I also use mine as security blankets. Speaking of security blankets, where did that phrase come from? I can tell you my mother did not invent it. Here is what Webster has to say about the phrase:
In the 1920s, a security blanket was placed over a sleeping child and fastened by clips. Although the security blanket did, indeed, secure the little one - essentially strapping him or her to the bed - the anchored blanket was designed so that in the event that the child became restless, he or she would remain snugly covered. Needless to say, this security blanket is now considered medieval.
In the American cartoon strip Peanuts, creator Charles M. Schulz’s character Linus Van Pelt carries around a blanket wherever he goes for comfort. Today, we refer to such an object as a “security blanket.” The emergence

of that sense of the term is contemporaneous with the first appearance of Linus with his blanket in 1954. That fact combined with the popularity of the Peanuts led many people to credit Schulz with the coining of the term. However, it can only be said that Schulz helped popularize a new sense of security blanket, since it was already being used in meanings much different decades before.
God knows that Linus and I are not related, but I do share common ground with him about the security blanket. I use them for comfort and I’m sure many of you do too!
I also looked up what the definition of blanket is. I was amused at how many definitions there were and that it can be used in so many ways! My team, during the brainstorming session, focused on blanket coverage, the kind that speaks to healthcare. They want to be sure that you are prepared to deal with your lupus and that you are covered through Medicare, Medicaid, Social Security disability, private health insurance for healthcare, and/ or prescription medication.
Although blankets are great and can offer comfort and security, we all need to learn more about “being covered” for the various challenges living with lupus may bring. I hope that some of this magazine’s articles will help you to do so. As fall approaches, do take the time to review all your coverings. Be ready when that rain and snow begin.


Suzanne Tierney President & CEO
Lupus Foundation of America, Greater Ohio Chapter
CONTENTS
Pg. 1 - 2 Letter from Suzanne
Pg. 4-5 Patient Navigator Corner: Sept 2024
Pg. 6-8 2024 Walk Recap
Pg. 9-11 Patient Story: Lea Waddell
Pg. 12-14 Patient Story: Roberta Sewolich & Jess Travis
Pg. 15-16 Be Lupus Ready!
Pg. 17-19 Research and News
Pg. 20-22 Applying for Social Security Disability When You Have Lupus: When is the Right Time?
Pg. 23 Blog and Podcast
Pg. 24-25 Could You Have Lupus?
Pg. 26 Staff Page
2022 1516 Be Lupus Ready! Applying for Social Security Disability When You Have Lupus: When is the Right Time? 6-8 2024 Walk Recap



1214 Patient Story: Roberta Sewolich & Jess Travis


The Patient Navigator program is funded in part by Aurinia Pharmaceuticals and an earmark from the State of Ohio and managed by the Ohio Department of Health.
In the last issue of “Living With Lupus,” the Patient Navigator Corner provided information about lupus journals and lupus flare plans, two very important tools to help patients manage their lupus symptoms. However, lupus impacts all areas of life, including finances.
Worsening lupus symptoms, medical emergencies, and unexpected events can quickly upend financial situations and require action. Do you have a financial plan in place to cover you in case of emergencies? Being prepared can save you and your family anxiety and stress and help you make decisions in a timely manner.
The Lupus Foundation of America has created a Caregiver Toolkit, in order to help lupus caregivers support lupians in their journey, including preparing for financial emergencies. According to the Caregiver Tookit: “Financial emergencies due to lupus can range from a limited, unexpected situation to a more permanent financial hardship. When planning, it is wise to set aside some emergency funds. Generally, an emergency fund should hold enough money to cover living expenses for at least three months, or more.”1 Consult with your financial planner or consider speaking to one to look at your overall financial situation and make a plan for emergencies.
In addition to setting aside emer-
gency funds, it is also important to make sure that you and/or a trusted loved one have gathered important documents in a safe and confidential location that you can easily access. The types of documents should include:
• Bank names and locations, account numbers, and types of accounts.
• Insurance company policy names, numbers, and types of insurance.
• If applicable, Social Security, Medicare, and Medicaid account numbers.
• Government or military work history, including supporting documentation.
• If you are currently employed, employer and employer’s human resources contact details and list of benefits they provide.
• Advance directives, durable power of attorney, and an upto-date will. If you do not have these documents, consider contacting an attorney to create them.
If you are suddenly faced with a financial emergency, here are some steps that you can take2:
• Evaluate the situation. What are the circumstances? What are your immediate and long term needs? If you or your caregiver
are working, will you need to take time off or apply for family medical leave (FMLA) if available?
• If you have short- or long-term disability insurance, consider applying to receive this benefit
• What if you (or your caregiver) lose your job?
• Consider filing for unemployment benefits. https:// jfs.ohio.gov/job-services-and-unemployment/unemployment/overview
• If you need help creating your resume, applying to a training or educational program to learn new skills, or deciding what type of job you would like to apply for, there are many job assistance programs that can help. Public libraries often offer these services for free.
• If you would like to work again, but you have disabilities that limit you from getting or keeping a job, Opportunities for Ohioans with Disabilities has programs that can help: https://ood.ohio.gov/information-for-individuals/oodworks/welcome
• What if you (or your caregiver) lose health insurance?
• If you lose your health insurance because you lost
your job, you may be able to keep your coverage through COBRA. “COBRA (the Consolidated Omnibus Budget Reconciliation Act) (dol. gov). COBRA is a federal law that may allow individuals and their families to pay to keep their health insurance, usually for up to 18 months. This gives individuals time to find other options for health insurance coverage.”1
• See if you are eligible for Medicare and/or Medicaid Coverage. Go to https://medicaid.ohio.gov/ or https:// www.medicare.gov/ for more information.
• You may decide to purchase your health insurance from the Health Insurance Marketplace https://www. healthcare.gov/. “The Marketplace website will allow you to compare coverage plans based on cost, benefits, and other features that may meet certain individual needs. If a person needs to sign up outside of the open enrollment period, they may have several options.”1
• Review your budget and prioritize expenses. If needed, do you have assets that can be turned into cash? Contact your financial planner, if you have one, to help you create a budget and manage expenses.
• Talk to lenders about negotiating a payment plan and talk with your bank representative about financial hardship options.
• Dial 2-1-1 for referrals to financial and community services.
• Go to https://lupusgreaterohio. org/find-resources/toolkit-forpatients/ to find links to many state and local government agencies and programs. Contact the local Human Services Department for information about emergency funds. There is also information and contact details of charitable or non-profit agencies that provide financial and other assistance.
• Go to https://www.lupus.org/ resources/financial-assistance to find federal government programs and national assistance organizations.
• Contact the Greater Ohio Chapter. We have assistance programs for help with food, out-
of-pocket healthcare expenses, transportation to healthcare appointments and mental health counseling through our partnership with Signature Health. If we do not have an assistance program that meets your needs, we can research other local and state agencies through the Unite Us platform.
Having a plan in place can help you prepare for financial emergencies and make them less stressful and overwhelming when they occur. If you would like to speak with a patient navigator about our assistance programs or other resources, please contact us at 1 (888) NO-LUPUS, (440) 717-0183, or info@lupusgreaterohio.org. We are happy to help!
1Caregiver Toolkit. Lupus Foundation of America. https://lupusgreaterohio.org/find-resources/ toolkit-for-caregivers/
2Coping With Financial Emergencies. Lupus Foundation of America. https://www.lupus.org/resources/ coping-with-financial-emergencies


The Walk to End Lupus Now® is a nationwide collection of events that aim to create awareness and raise money for research to find the cause and cure of lupus. For over 25 years, the Lupus Foundation of America, Greater Ohio Chapter has worked tirelessly to build each walk into a fun-filled community gathering that celebrates lupus patients and their friends and family.
We would like to extend a heartfelt thank you to the entire Ohio lupus community for participating in the 2024 Walk to End Lupus Now®! This year we all joined together at the Center of Science and Industry (COSI) in Columbus on August 17th and on the east bank of The Flats in Cleveland on September 14th to walk in unison toward a lupus-free future.
Both days showcased the strength, tenacity, and camaraderie shared by all lupians and their loved ones. In the simplest of terms, the walks are a peerto-peer fundraiser. But they also serve as a reminder that no one is, nor should be, alone on their lupus journey. With almost 1,000 individual donations, 500
participants, and over $60,000 raised, our Ohio lupus community proved that there truly is no “i” in lupus.
The monies raised at our Walk to End Lupus Now® events are the bedrock of our organization. They fund educational

programming, vital research to find a cause and a cure for lupus, advocacy, medical literature, support programs, and more. Each dollar raised helps us to continue the fight to end lupus, not only here in Ohio, but across the country. We cannot thank our participants and donors enough. You may not
realize the impact you have, but it is massive!
A huge congratulations to this year’s top fundraisers Rosie Chapman (Columbus) and Tanya Quinones - Santiago (Cleveland)! These two powerhouses raised a combined $10,000 and will have the privilege of rep -
resenting our chapter in Washington DC at the 2025 Lupus National Advocacy Summit! Great job ladies!
Thank you to everyone who registered, formed a team, donated, shared, posted, shouted or otherwise helped spread the word about this year’s walks! It truly does take a village and we are fortunate to have such strong support throughout the state. Thanks to all of our

- Flower Entertainment: Balloon Clown and Face Painter
- Ellory Smith - DJ
- Steve Campbell - Caricature Artist
- All The Hoopla
- Giant Eagle
- MetroHealth
- Hoop To The Rhythm

volunteers who helped on the day of each walk and those who came into the office to help with the copious amounts of preparation and planning involved.


- Terri Krieder
- Stephen Perhach
- Lisa Bordner
- Kelly Perhach (Just a Little Lupie)
- Tiffany Thiede (Team: Thiede & Fergi Butterflies)
- Marybell Moyet (Flare Fighters)
- Leslie Tierney (Lupus Angels)
- Shawntee Johnson (Purple Joy)
- Latasha Adams ( Cheftash YOU GOT THIS!!)
- Hannah Powell (Team: Walk With Hannah)
- Nicole Corley (NicNac Wolf Pack)
- Laura Biernacki (Knockout Lupus)
- Shelby Seibert (Team Shelbs)
- Ariel Shelton
- Tayna Quinones-Santiago
- Rosie Chapman

Do you have suggestions for next year’s Walk to End Lupus Now®!? Keep an eye out for the opportunity to share your ideas. If you’d like to help with next year’s walk, reach out today to join the 2025 Walk Committee!
Contact our Digital Assets and Office Manager, Alex Acevedo. Alex@lupusgreaterohio.org (440) 717-0183 Congratulations to Our Top Fundraisers!

By Lea Waddell
Hi, I am Lea (pronounced as Lee). I am in my fifties and living in Ohio. I have lupus, and I was diagnosed twenty-one years ago. It took several years and many doctors to finally get an answer as to why I felt so bad. It started with joint pain, low grade fevers, mouth sores, pleurisy, and muscle pain and weakness. Then I finally found a doctor on the advice of a friend, and he gave me an answer to what was happening to my body. The most important thing was it was not all in my head as some were trying to tell me. So here are some ways I have learned how to “cover myself” so I can take care of myself.
My Family!
I have such great support from my family. They are always there to help me when I need it or when I need to just talk. I have a husband and three children, all grown, married and out of the home. I have
three wonderful grandchildren, and they are the best medicine I have been given!
My husband has been a major support to me with his love and understanding. His understanding of my illness has increased because he also was diagnosed with an autoimmune disease. Life for us has not been easy, but we make it work. We love each other and take care of each other.
I have learned that soft, comfortable clothes are a must! I like soft loose clothing that does not bind, because there are days that it just hurts to wear anything. Socks are a staple I cannot go without even in the summer months, and I wear wool in the winter. My feet are always cold; so if they are warm, then I can usually keep my body warm. I have a love for soft t-shirts that usually have either bands
or are from the books I read. The weirder the better!
Books!
I have always been a big reader, and since there is a lot of down

time, I have become even more so. It is my escape from my reality and a little reprieve from the pain. Reading for me is a way to live through others or just escape into another reality depending on what type of book I am reading. And I like to read all kinds of books. I also sew. I have been sewing since I was little and love to create interesting things. It helps me to have something else to focus on that does not include what is happening to my body.
Tea is another of the things that is comfortable to me. Hot Earl Gray in
the morning on a chilly day goes a long way to warm up the bones. I drink iced tea in the summer.
Heating pads are such a wonderful thing! I go for the bigger the better to cover more areas. The heat helps with the achy joints and sore muscles to get a little relief. I have them anywhere I sit for any length of time. I also use pain relief rubs or patches and essential oils.
I think the biggest thing that helps is to listen to your body. And what I mean by that is your body will tell you what you need. This was


“Reading for me is a way to live through others or just escape into another reality depending on what type of book I am reading.”
one of the hardest things to learn, because at first, I did not want to admit I was sick and could not do the things I did before. I would just go and go till I would wear myself out, and it would take weeks to recover myself. I have learned to pace myself and take things slower and plan ahead. You must learn what your limits are and how to do the things you loved before in a way that you do not run yourself down so badly. Stress is a major trigger for me. But listening to your body and learning what you can manage and then figuring out ways to do the things you used to
love to do is amazing. It gives you a way to live with this disease and still live your dreams.
I love the spoon theory. It is a way to help measure and manage your energy everyday. Each spoon represents the amount of energy that you have and you can use to do tasks or activities during your day. So, you start your day with so many spoons in your drawer, then as you do things you use your spoons up. Some days just getting out of bed takes many spoons, and some days you have extra spoons in your drawer at the end of the
day. The trick is learning each day how many spoons it takes to do what you need to do and how to spread the spoons out.
Listening to your body is the only way to get your life under control and learning to live with your limits, which is how you live with your lupus. Each of us is affected differently by our lupus, and some of the things I find that help may not be for you. But, if even one of these helps, I hope you can find some comfort in that. Hang in there and know you are not alone in this fight. We are all in this together, so

“Some days just getting out of bed takes many spoons, and some days you have extra spoons in your drawer at the end of the day.”

By Roberta Sewolich & Jess Travis
Roberta Sewolich
I have always been a walking anomaly. My symptoms came on one by one. First there was hair loss, then a painful face rash, joint aches, fever for no reason, exhaustion, weight gain, and sun sensitivity. The butterfly rash would be so obvious that people would comment about me being out in the sun and getting sunburned. I started wearing foundation daily to cover the rash so I wouldn’t have to keep explaining. My doctors would dismiss each symptom by saying it was stress, age, and other generalized issues. One doctor even told me that I should just meditate to ease the stress and pain.
Finally, a doctor’s visit and a blood test told the story of why I was going through these issues: I have lupus. I could deal with that, but the most painful and mysterious
symptom was chronic pancreatitis. I spent many visits in the emergency room doubled over in pain. But the doctors didn’t seem to connect the lupus with the pancreatic pain. After ruling out the other causes, the doctor finally figured out the lupus was attacking my pancreas. I had been through so many tests, several surgeries, and many
doctors, only to find out that this was something that I was going to live with for the rest of my life. My pancreas finally stopped working completely and shut down. I am now a type 1 diabetic. After this, my lupus started progressing by attacking my liver. I also started getting migraines and heat sensitivity. I have become so sensitive to


heat, that I sometimes get nauseous just vacuuming the house.
The worst was when I started noticing that my daughter, Jess, began experiencing similar symptoms. I told her to have her doctor run tests to check her for autoimmune diseases, because my brother also has an autoimmune disease, and maybe it is genetic. She was having migraines, heat sensitivity, insomnia, joint pain, and the ever-lovely butterfly rash. Her doctors were, at first, reluctant to evaluate her because she didn’t have enough “symptoms.”
Finally, her doctor agreed to test her. Surprise, she has lupus. We are now each other’s support system for the disease. We make sure we are out of the sun, drinking plenty of water, and resting when our bodies say to rest. It is a sad situation knowing what she is going through now, and what she will go through in the future as her illness progresses.
It has helped us to understand how every day can be different with this disease. You never know where or how the disease is going to affect you. You can’t make
others understand what we battle daily. We have to do what we can when we can because the next day might be a lupus day. It never takes a rest, and those that don’t have it think everything is fine because you “don’t look sick.” But all the while, you are in pain with every movement and suffering a migraine, and you want to stay in bed all day because your body is so exhausted.

Jess Travis
Being officially diagnosed with lupus ended up being one of the least distressing events in a period of my life filled with grief. In the summer of 2021, I lost my husband to suicide. A year later, I got my ANA test results - which said what I knew it was going to say - that it was positive, and the pattern indicated lupus. Even though I expected it, seeing the results on the screen was tough. Even tougher was getting in to see a rheumatologist. My doctor put in a referral
as soon as the results came in, but when I got the call to schedule the appointment, the best available was six months later - if I was willing to go to an office a bit further away. If I wanted my preferred location, the wait was over a year. I froze on the phone with the scheduler; I didn’t know what to say. I took the appointment that was six months away and prepared to wait.
In the grand scheme of things, six months wasn’t that long. I had
been battling almost daily headaches, fatigue, body aches, and mouth sores for years. Honestly, I consider myself lucky that my mother also has lupus, because as she said, she saw all the warning signs and pushed me to keep asking my doctors about it. She noticed my cheeks were inflamed, and I started showing signs of sun sensitivity. She also noticed that I complained of constant headaches, and my knees didn’t feel like working. It made me feel like I wasn’t alone - one of the
I can say that I am constantly impressed with the strength of my fellow ‘lupies.’
biggest hurdles for patients with this awful disease. If I hadn’t grown up watching her fight lupus, how long would it have taken me to realize what was going on?
The final straw for me was the confusion. It is called brain fog, but for me, it was so much scarier than that. I would suddenly find myself in the kitchen, just looking around. I couldn’t remember why I was there, or if it had even been my intended destination. Had I meant to go into the living room? What was it that I needed? Sometimes I couldn’t remember, so I would try to make the best of it and wash the dishes while I was there. The memory and cognition issues started affecting my work; I would forget what I was saying in meetings, and I would forget what tasks I was doing while in the middle of doing them. And those were just the times I had enough energy to sit at my desk. Some days I would wake up and be so exhausted that the thought of having to be a person made me cry. Almost every day needed to include a nap.
So, I waited six months for my new patient appointment at the rheumatologist. It was a bit of a letdown to tell the truth. To me, this was a huge deal. To the doctor, I was a patient - and I had the same issues as all her other patients. I’m sure most of them were in more dire straits than I was. The doctor did all the routine tests, moving my arms and legs here and there, and feeling my joints. She ordered tests, and I had my blood drawn.
When they came back, my internal inflammation levels were extremely high, I was put on Plaquenil, and I was diagnosed with Sjogren’s. I was referred to a neurologist for constant headaches, a sleep doctor for excessive fatigue, and a psychiatrist for the possibility that some of my symptoms were stemming from PTSD and grief rather than lupus. As I write this, I am still
a few weeks away from seeing the neurologist.
The wins are sometimes hard to see, but they’re there. I take a few less naps now than I did a year ago. I find myself standing in the middle of a room confused less often. Most precious to me is that my mother and I have come to appreciate and celebrate each other on a deeper level. It shouldn’t have taken me such a long walk in her shoes, but having done it, I can say that I am constantly impressed with the strength of my fellow ‘lupies.’

By: Adrienne Rice-Fernandez

Fall is my favorite time of the year. I love the leaves changing color, the smell of a campfire, and the temperature change. But for many of us lupus patients, a change in seasons comes with a change in symptoms. Cold weather can trigger lupus and make symptoms worse.
Cold temperatures are known to cause migraines. They also cause blood vessels to constrict which reduces heat loss and can result in small blood vessel spasms which restrict blood flow. This can cause pain, swelling, and tissue damage in the extremities. In addition, many lupus patients complain of additional fatigue and brain fog during the colder months. And most lupus patients can attest to an increase in pain during changes in bariatric pressure. If this is your first winter living with lupus, my advice is don’t be scared, be prepared! What things can be
done to help prepare you for the cold months ahead? Consider the following:
1. Make sure to buy a pair of insulated gloves, socks, and a winter hat.
2. Look into hunters’ socks. These socks are designed to keep your feet extra warm.
3. Invest in a pack of hand warmers (and foot warmers if needed), to stave off any Raynaud’s attacks.
4. Make sure your car has extra blankets and clothes in case you need more coverage.
5. Buy a space heater for extra comfort. But be sure to follow all safety precautions!
6. Dress in layers. This helps to keep the joints more flexible, reducing stiffness and cold-induced discomfort.
7. Avoid long-term cold exposure. It’s probably not a great idea to book a holiday camping excursion! If you like to ski, bundle up and wear your SPF.
8. Keep an exercise program as part of your regular schedule. Exercise improves blood flow and helps to regulate body temperature. It also strengthens muscles and prevents joint damage and weakening. Your exercise program should be doctor-approved.
9. Drink warm beverages like tea and a honey/lemon/water combination. Coffee and hot cocoa are good selections but watch for sugar and caffeine.
10. Make sure your home is well insulated. For home weatherization assistance in Ohio, visit;
https://development.ohio. gov/individual/energy-assistance/6-home-weatherization-assistance-program.
It isn’t only winter that lupus patients need to be prepared for. It’s good to be lupus-ready at all times. What does this mean? It means ensuring you are positioned to help prevent a flare and have a plan in place when you have one.
How can lupus patients help prevent a flare? There are many ways, but these are the most common:
1. Get enough sleep. A full 7-9 hours of sleep at night can help mitigate lupus fatigue, prevent flares, improve brain fog, and improve immune system function. If you are not getting enough sleep at night, try to schedule time for a 15 to 30-minute power nap during the day.
2. Protect yourself from UVA and UVB light. Different reports suggest that 70% of people with lupus are photosensitive. Researchers haven’t discovered why this is true. So, we lupus patients must wear sunscreen every day. Wearing hats and investing in SPF clothing is another way to protect your skin. Some patients even work with their doctor to get a special tint on their car windows.
3. Get enough vitamin D. The sun is the best natural source of vitamin D. Since most lupus patients avoid the sun, they are often deficient in vitamin
D. Work with your doctor to ensure you get enough vitamin D in your diet and supplement what you are missing. If you cannot get enough in your diet, a prescription or over-the-counter supplement may be necessary.
4. Eat a healthy and diversified diet. Get enough greens, protein, and healthy carbohydrates. There is not a specific diet known to help lupus, but a well-balanced one with plenty of fruits, vegetables, lean protein, and grains is recommended for all people with chronic illnesses.
5. Exercise. Work with your doctor to devise a heart-healthy exercise program. Make sure what you devise is doable for you. You may not be able to run a marathon, but perhaps you can walk two miles up to three times per week. Or maybe yoga is a good fit for you. Whatever you choose, ensure that your doctor is on board.
6. Reduce Stress. Stress is a known trigger of a lupus flare. All of us have to face life’s challenges. As much as we would like to have no stress, that often isn’t possible. Practice things like meditation, gentle yoga, tai chi, reading, journaling, deep breathing, and listening to music to help reduce the stress in your life. Make time to do one of these things every day!
7. Reduce exposure to illness. Lupus patients are often immunocompromised. This is either due to medications or
the disease itself. Take steps to protect yourself. If illnesses such as COVID, or the Flu are going around, mask up! Or, if you are going to an event with many people, wear a mask and practice social distancing. And don’t forget to wash your hands and keep them away from your face. If you do get sick, make sure to inform your doctor.
Following these suggestions can help keep your body in a healthy state. But if a flare happens, there are ways to ensure you are ready. One way to prepare for a flare is to fill out The Lupus Foundation of America’s “Your Lupus Flare Plan” (see QR code below). This helpful tool is designed to help you, and your doctor, have a plan in place when you are unwell. Take the plan to your doctor in advance so you agree on the plan together. Keep the worksheet with you so you can refer to it if necessary.
The most important thing to remember is that you can live well with lupus. It just takes extra preparation and extra self-care. When a flare happens, be prepared, and ensure you have a support system and an open line of communication with your doctor. And always make your health a priority. Go to your doctor’s appointments, schedule any tests they order, and be lupus-ready!
Lupus Flare Plan QR Code:



A new study published in Lupus Science & Medicine found an advanced neuroimaging method called a structural MRI can identify total and regional brain abnormalities associated with cognitive dysfunction (CD) in people with systemic lupus erythematosus (SLE). CD is highly prevalent in people with SLE, characterized by clouded thinking, confusion, and impaired memory.
Researchers examined the findings of 18 advanced imaging and CD studies conducted on groups of people with SLE ranging from 11 to 120 participants. They discovered advanced structural MRI
analysis revealed brain abnormalities associated with CD. The most frequently affected cognitive areas were memory, psychomotor speed, and attention. Abnormal structural and/or diffusion MRI results were more often found in the hippocampus, corpus callosum and frontal cortex of the brain in people with SLE, regardless of if they were also diagnosed with central nervous system involvement.
Using advanced neuroimaging in people with SLE can help discover the underlying causes of CD as well as other brain-related symptoms such as mood disorders,
and can potentially help in the development of biomarkers and diagnostic tools for neuropsychiatric lupus. Overall, more exploration of advanced neuroimaging methods is needed in SLE-related CD, including for establishment of outcome measures in clinical trials focused on therapeutics and preservation of cognitive function in SLE.
Learn More: https://bit.ly/4epYn8t

In a new study, researchers examined the efficacy and impact of CD19 CAR T cell therapy on B cells, specifically exploring its ability to deplete B cells in deep tissues and understand the therapeutic potential for people with autoimmune diseases, like lupus. CAR T cells are genetically-altered cells that are designed to reset the immune system by targeting B cells, which are involved in the production of autoantibodies and lupus disease activity.
Researchers analyzed lymph node biopsies from five people with autoimmune diseases before and after CD19 CAR T cell therapy. These biopsies were
compared against five people with autoimmune diseases after rituximab treatment, and were also compared to non-lymphoid organ (colon, kidney, gallbladder) biopsies from three people with autoimmune diseases after CD19 CAR T cell therapy. After CD19 CAR T cell therapy, CD19+ and CD20+ B cells as well as follicular dendritic cells (cells of the immune system found in the lymph nodes of B cell areas of lymphoid tissue) were depleted in the lymph nodes, whereas plasma cells, T cells and macrophages remained unchanged. People on rituximab treatment did not achieve B cell depletion, which suggests CD19 CAR T cell therapy could be a more effective treat-
ment for autoimmune diseases, including lupus.
The findings underscore the necessity of tissue analysis following B-cell depleting therapy to measure the extent of the treatment’s impact. Learn more about treatments being studied for lupus and sign up for a free, virtual webinar on CAR T cell therapy on Thursday, September 19.
Learn More: https://bit.ly/47rRp0t

When people with systemic lupus erythematosus (SLE) actively participate in shared decision-making (SDM) about their disease with their doctors’, trust is likely to increase. A new study found that patient-doctor SDM increases trust and enhances the doctor-patient relationship, as well as overall confidence in healthcare, treatment efficacy and treatment options.
In the TRUMP2-SLE study, researchers asked 433 people with SLE across multiple health centers in
Japan to complete a SDM questionnaire. Their responses were scored for interpersonal trust with a physician and trust in the medical profession using two different measurement models. An analysis of the responses of the questionnaire found that, at 1-year mark, the more people with SLE that were involved in SDM with their physician, the more likely they were to have established greater trust in their rheumatologists and general physicians.
Improvement in physician trust through deep involvement in shared decision-making can improve behavioral and health outcomes. Learn more about preparing for your doctor appointment.
Learn More: https://bit.ly/47CofvB


By Emily E. Warren, Esq.

The Social Security Administration recognizes Lupus as a medical condition that may prevent a person from working, resulting in an approval of disability benefits. To know when the right time to apply is, you should: understand the basic rules for each of the two Social Security disability benefit programs, review the medical and non-medical requirements of each program considering your own personal situation, and discuss with your medical provider whether he or she will support you in the disability process.
Social Security Disability Insurance and Supplemental Security Income Benefits
The two Social Security administered disability programs are called Social Security Disability Insurance (also known as SSDI) and Supplemental Security Income (also known as SSI). To be eligible to file for disability, you must meet the requirements of one of these two programs.
The SSDI program will look to your ten most recent years of work history to determine if you are eligible to participate. Each year you have the opportunity to earn up to four work credits by working and paying into the Social Security program. The dollar amount you must earn to gain one credit varies by year, but for 2024 you would need to earn $1,730 to earn one credit or $6,920 to earn all four credits for the year. Looking backwards, you must have earned 20 of the last 40 credits (preceding the date you became disabled) to participate in the SSDI program. In short, if you have worked (full-time) for five of the past ten years, you will be covered. The monthly benefit amount you would be entitled to will depend upon how much you have worked, earned, and paid in to the Social Security system over the life of your work history. Nonwork income will not impact your monthly benefit rate, but income from work activity might. If approved, you would also be entitled
to Medicare benefits approximately 29 months after the first day that Social Security determines your disability began. These benefits may be paid up to one year prior to the date on which you filed your application.
The SSI program is based on financial and medical need. It looks at your family’s total resources to determine whether you are eligible to participate. As a family, you are not allowed to have more than one vehicle, one home (that you must also reside in), or resources of greater than $2,000 (as a single individual) or $3,000 (as a married person). The monthly benefit rate fluctuates by year, but currently the maximum monthly benefit rate is $943/month for an individual or $1,415 for a couple. If your resources exceed these limits, even after disability is approved, your benefit may be reduced or eliminated. The earliest date benefits could be paid under this program is the date of application. If your claim is ap -
proved, you will also be awarded Medicaid coverage.
The medical definition of disability under both the SSDI and the SSI programs is the same. You must be unable to work and engage in substantial gainful activity (SGA). This means you must not be able to earn more than the SGA amount each month. For 2024, SGA is $1,550. Therefore, you must be unable to work and earn $1,550 or more, as a result of your medical impairment(s). Also, it must be expected that your medical impairment(s) will keep you from working and earning this month for at least a period of twelve months. But, to be clear, you do not have to wait twelve months to file your application, you simply must have a reasonable belief that your condition will last that long at a level that would prevent you from earning SGA.
Not every medical diagnosis entitles you to an award of Social Security disability benefits. The condition must, first, be a medically determinable impairment,” which is a term of art defined by Social Security as:
A physical or mental impairment must result from anatomical, physiological, or psychological abnormalities which can be shown by medically acceptable clinical and laboratory diagnostic techniques. The impairment must be established by objective medical evidence (signs, laboratory findings, or both) from an acceptable medical source, not on an individual’s statement of symptoms. 1
This condition must then meet additional criteria. It must either meet all of the requirements of a specific “listing” published by Social Security or your impairment or combination of impairments must prevent you from performing your
past work or any other work that exists in the national economy in significant numbers.
For individuals seeking to receive disability benefits as a result of their Lupus diagnosis, the specific “listing” that must be met is Listing 14.02 – Systemic Lupus Erythematosus (SLE)2. Your Lupus diagnosis can meet the requirements of this listing in one of two ways. The first way to establish that it meets the listing is to show that two or more of your organs/body systems are involved, with one of the organs/ body systems being involved to at least a moderate level of severity, and, you must have at least two of the constitutional symptoms or signs of lupus (Severe Fatigue, Fever, Malaise, or Involuntary Weight Loss). The second way you can establish that your Lupus diagnosis meets the criteria for this “listing” is to show that you have had repeated manifestations of SLE, with at least two of the


Emily Warren heads up the ERISA litigation section of Margolius, Margolius and Associates and has over 15 years of litigation experience in this area. She has worked extensively on ERISA / Long Term Disability, SERS, OPERS, STRS, and Social Security disability cases since joining the firm. Emily is a highly proficient writer and has enjoyed significant success at the Federal Court level in appealing Social Security disability cases. Emily also enjoys litigation in the civil rights areas of housing and employment discrimination. She handles these matters before the Ohio Civil Rights Commission (OCRC) and the Equal Employment Opportunity Commission (EEOC) and litigates these cases in Ohio state courts and the U.S. Northern and Southern Districts of Ohio. In addition, Emily champions the rights of the disabled working on ERISA disability claims (short and long term disability) in both the U.S. Northern and Southern Districts of Ohio and the U.S. Sixth Circuit Court of Appeals, advocating for an expansion of employee rights under ERISA. She has made this area of the law, which notoriously favors large insurance companies, one of her primary focuses. She is a past Chair and the current Treasurer of the Cleveland Employment Lawyers Association.

constitutional symptoms or signs (severe fatigue, fever, malaise, or involuntary weight loss) and one of the following limitations at a marked level: Limitation of activities of daily living; or Limitation in maintaining social functioning; or Limitation in completing tasks in a timely manner due to deficiencies in concentration, persistence, or pace. For clarity, Severe Fatigue means frequent exhaustion resulting in low activity. In order for Fever to be considered, it must not be caused by anything other than your SLE. Finally, Malaise means frequent feelings of illness or bodily discomfort (pain).
Even if your SLE does not meet each of the requirements of this Listing, you may still be entitled to disability. An alternative to meeting a Listing is to show that
you have an impairment or combination of impairments that, when considered singly or in combination, renders you unable to sustain work activity.
If, after discussing your condition(s) with your doctor, you believe that you are ready to file for disability, you may do so in several ways. If you will be applying for

both SSDI and SSI or just SSDI, you can file online at www.ssa.gov. You may also apply for either or both programs by going to your local social security office and doing so in person, or by calling the national Social Security hotline (1-(800) 772-1213), following the prompts for disability (until you get a live person on the phone) and asking them to make you a phone appointment to file for disability benefits.
Thanks to the Lupus Foundation of America, Greater Ohio Chapter, you can give your loved ones a customized revocable living trust, which includes legal review, pour-over wills, power of attorney, and medical directives for them and their spouse, PLUS 5 years of emergency medical card services — for just $2,450. It’s simple, easy, and very meaningful.
Set up a free appointment at 440-638-5224 or email lupuslegacy@interventionpoint.com



If you would like to share your story, or have a topic you think would benefit lupus patients, contact our shows producer Alex by email: Alex@lupusgreaterohio.org
Check out our channel: @lupusgreateroh
Suzanne sits down with Steve Morris of Intervention Point to discuss the benefit of setting up a trust and what it could mean for your family. Not only can they provide security, and peace of mind, but also keep the courts and government from complicating things when that time comes. To learn more about setting up a trust email lupuslegacy@interventionpoint.com
Suzanne is joined by Hannah Powell, a relatively newly diagnosed patient who has already had her fair share of trials and tribulations. Hannah talks candidly about her diagnosis, the challenges she faced and what finding the Walk To End Lupus Now has meant to her.
Suzanne sits down with Steve Perhach to talk about his experience with being married to someone with lupus. Steve’s wife, Kelly, is a brave lupus warrior who has had her share of ups and downs throughout her journey. They are both heavily involved in their community and spend time volunteering at various organizations .
Our blog, Lupus Night Light, is a place where we share stories and practical advice from patients that they have learned along their lupus journeys. You will find stories of triumph, hardship, and everything in between. It is meant to be a cathartic journey for both the contributors and readers alike.

Have you had a seizure or convulsion?
Have you had unexplained confusion that lasted more than an hour?
Have you had unexplained fever higher than 100º F/38º C for more than a few days that was not due to infection?
Have you felt chest pain while taking deep breaths?
Have you had a stroke or heart attack?
Have you been told you have protein in your urine?
Have you had swelling in your legs and ankles on both sides at the same time?
Have you been told you have anemia, low white cell count, or low platelet count?
Have your fingers and/or toes become pale or red or blue, or felt numb or painful?
Have you had blood clotting problems or a miscarriage?

Have you had sores in your mouth or nose that lasted more than five days?
If you have had any symptoms like these, especially if you have had several, talk to your doctor about lupus. Early diagnosis and proper medical care are the best ways to manage lupus.
Have you developed irritation or dryness in your eyes or mouth for more than a few weeks?
Have you had unexplained weight loss or abdominal pain or tenderness when your belly is touched?
Have you had stiff, tender, and swollen joints that feel worse in the morning?
Have you had extreme fatigue and weakness for days or weeks at a time, even after plenty of sleep?
Has your skin broken out after being in the sun, but it’s not a sunburn?
Have you had redness or rash across your nose and cheeks in the shape of a butterfly?
Have you had sores on your skin that would not heal?
Have you had sudden, unexplained hair loss?
Lupus is a chronic autoimmune disease that causes inflammation in various parts of the body. The disease can r a nge from mild to li f e - threatening. Ninety percent of those d i a g n osed with lupus are females between ages 15 and 44, but lupus also occurs in men, older people, and children. Lupus can be very hard to diagnose because symptoms vary from person to person, can come and go, and can mimic symptoms of other illnesses. is important to know the symptoms of lupus and to know if you are at risk for this disease. Here is a simple test to help you. Read each question and answer it in terms of your current AND past health. Please

Ohio Chapter Programs Available:
Let's Talk About It Webinar Series
Living with Lupus Magazine
Lupus Night Light Blog My Lupus Living Room Podcast
Patient Navigator Program
Educational Summits & Classes
Support Groups
Local State Advocacy

The Lupus Foundation of America is the only national force devoted to solving the mystery of lupus, one of the world’s cruelest and devastating diseases, while giving caring support to those who suffer from its brutal impact. Through a comprehensive program of research, education, and advocacy, we lead the fight to improve the quality of life for all people affected by lupus. Contact the LFA or a chapter that serves your area to find out how you can become involved in our mission and how we can help you.
Suzanne Tierney, CEO/President Suzanne@lupusgreaterohio.org

Kathy Holmes Finance Manager
Kathy@lupusgreaterohio.org
I was diagnosed with lupus in 1989 and joined the Lupus Foundation of America, Greater Cleveland Chapter the same year. I have been able to grow with the organization, as it became the LFA, GOC. Knowing how important it was to have somewhere to turn when I was first diagnosed is what motivates me to do all I can to help our chapter continue in our mission. Being in remission for the past 20 years has enabled me to take an active part in the growth of our chapter.

Mackenna Willis Creative Design Manager
Mackenna@lupusgreaterohio.org
I’m the marketing manager and creative developer when it comes to strategizing new ideas for Lupus awareness. As a graduate from Bowling Green State University with a BFA in graphic design, I’ve always envisioned utilizing my skills to make a difference. My enthusiasm to help others through design has always been a passion of mine and having the opportunity to share and grow with the LFA, GOC team has been nothing but inspiring.
I have spent the last 30 years dedicated to the lupus patients in Ohio. The goal is to provide a better quality of life until a cause or cure for lupus is found. My passion is providing programs to empower those affected by lupus so that they will have a better journey with lupus through education and emotional support. Lupus does not have to be a lonely, miserable, and misunderstood illness. My goal is to provide my chapter with the tools and resources to provide such services to all those in the state of Ohio.
Rita O. Piccin, BS, ND, RN Lead Patient Navigator /Outreach Coordinator
Rita@lupusgreaterohio.org

chapter continue to grow and help lupus patients for years to come.
I am a caring, collaborative, and resourceful nursing professional with over 30 years of experience in a variety of roles. I have a BS in Biology and French from John Carroll University and a Doctor of Nursing degree from Frances Payne Bolton School of Nursing at Case Western Reserve University. I am passionate about giving effective and empathetic customer service and education to patients, caregivers, families, colleagues and community organizations. I am honored to be a part of the LFA,GOC and dedicated to providing education, support, and resources to lupus warriors.

Community Outreach Coordinator
Aletha@lupusgreaterohio.org
two wonderful sons, they are the reason I fight lupus daily. I share my story everyday hoping that it might help or encourage someone else on their journey. I try to leave lupus patients with these thoughts and that is keep your environment positive in all aspects and do what you can

Chris Milazzo Event Assistant
Chris@lupusgreaterohio.org
Helping others has always been one of my greatest passions. After graduating from SUNY Oneonta with a degree in Media Studies, I knew I wanted to use my degree to do good. Being able to work for the LFA, GOC has been one of the most rewarding experiences in my career so far. It brings a smile on my face knowing that the work I do is able to help the lupus community of Ohio, and I hope to continue being a helping hand for the community.


www.lupusgreaterohio.org
THANK YOU FOR READING OHIO’S LUPUS MAGAZINE! FOR THE MOST UP-TO-DATE INFORMATION FROM THE WORLD OF LUPUS, PLEASE VISIT US AT WWW.LUPUSGREATEROHIO.ORG
THE FUNDING FOR THIS CAMPAIGN IS FROM AN EARMARK FROM THE STATE OF OHIO AND MANAGED BY THE OHIO DEPARTMENT OF HEALTH.
EMAIL INFO@LUPUSGREATEROHIO.ORG WITH ANY QUESTIONS OR CONCERNS.
GET IN TOUCH!
Lupus Foundation of America, Greater Ohio Chapter 12930 Chippewa Road, Brecksville, OH, 44141
Phone: (440) 717-0183 Toll-free: 1 (888) NO-LUPUS FOLLOW OUR
@lupusgreaterOH